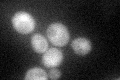
YIL153W
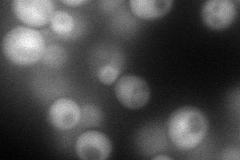
YIL153W
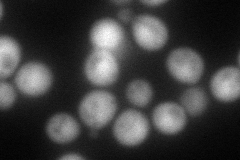
YIL153W
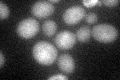
YIL153W

View description
Peptidyl-prolyl cis/trans-isomerase, activator of the phosphotyrosyl phosphatase activity of PP2A; involved in G1 phase progression, microtubule dynamics, bud morphogenesis and DNA repair; subunit of the Tap42p-Sit4p-Rrd1p complex
Localization:
Intensity:
Fold change:
Significance:
-
C’ GFP library in SD
cytosol29.32 -
N' NOP1pr-GFP in SD
cytosol90.9045 -
N' TEF2pr-mCherry in SD
cytosol97.6222 -
N' NATIVEpr-GFP in SD

cytosol27.802 -
N' TEF2pr-VC and Cyto-VN in SD

cytosol47.1454 -
C’ GFP library in SD+DTT

cytosol35.711.21No -
C’ GFP library in SD+H2O2

cytosol29.681.01No -
C’ GFP library in Starvation Media
cytosol48.81.66Yes -
C’ GFP library on the background of Pup2-DaMP

cytosol -
C’ GFP library on the background of CCT mutant

cytosol29.91711.02002No
